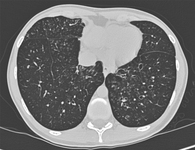
7

Imagens e vídeos
IMAGENS

Bronquiectasia
Brônquios com muco retido em uma mulher de 36 anos de idade com aspergilose broncopulmonar alérgica
De Pamela J. McShane, MD; uso autorizado
Veja esta imagem em contexto nas seguintes seções:

Bronquiectasia
Tomografia computadorizada do tórax com a presença de anel de sinete à esquerda
Dos arquivos do Dr. Sangeeta M. Bhorade; uso autorizado
Veja esta imagem em contexto nas seguintes seções:

Bronquiectasia
Tomografia computadorizada do tórax com vias aéreas dilatadas e espessadas e um padrão de árvore em brotamento
Dos arquivos do Dr. Sangeeta M. Bhorade; uso autorizado
Veja esta imagem em contexto nas seguintes seções:

Bronquiectasia
Situs inversus (síndrome de Kartagener) em uma mulher de 19 anos de idade com bronquiectasia focal devida a discinesia ciliar primária
De Pamela J. McShane, MD; uso autorizado
Veja esta imagem em contexto nas seguintes seções:

Bronquiectasia
Sinais do anel de sinete em uma mulher de 20 anos de idade com bronquiectasia
De Pamela J. McShane, MD; uso autorizado
Veja esta imagem em contexto nas seguintes seções:

Bronquiectasia
Radiografia torácica com vias aéreas dilatadas e espessadas
Dos arquivos do Dr. Sangeeta M. Bhorade; uso autorizado
Veja esta imagem em contexto nas seguintes seções:

Bronquiectasia
Radiografia de tórax com ausência de afunilamento normal, produzindo linha de trem
Dos arquivos do Dr. Sangeeta M. Bhorade; uso autorizado
Veja esta imagem em contexto nas seguintes seções:

Bronquiectasia
Bronquiectasia cística e varicosa grave em um homem de 49 anos de idade com bronquiectasia idiopática e escoliose
De Pamela J. McShane, MD; uso autorizado
Veja esta imagem em contexto nas seguintes seções:
Vídeos
 Sibilos expiratórios
Sibilos expiratóriosSons de ausculta: sibilos expiratórios.
 Estertores inspiratórios iniciais
Estertores inspiratórios iniciaisSons de ausculta: estertores inspiratórios iniciais
O uso deste conteúdo está sujeito ao nosso aviso legal